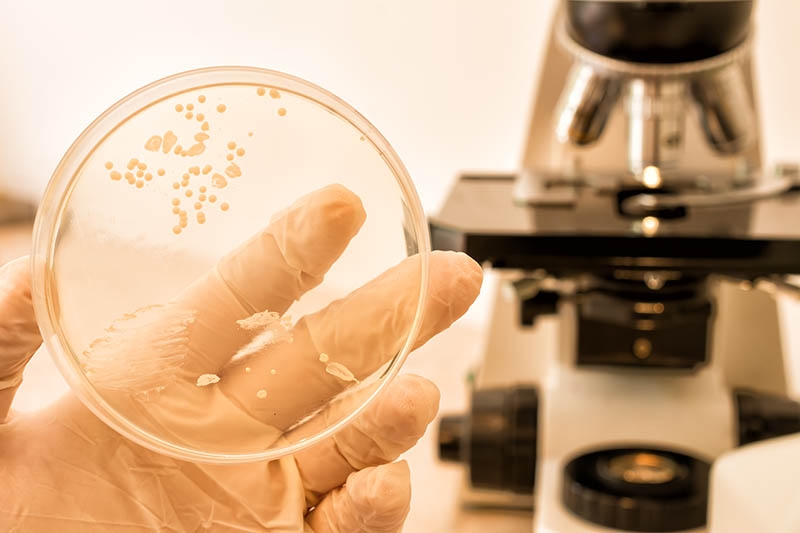
Грибки у статевих органах

Гриби живуть скрізь: у ґрунті, у повітрі і навіть у людському тілі. Їх не можна виявити неозброєним оком через мікроскопічні розміри. При настанні сприятливих умов вони здатні швидко розмножуватися та паразитувати. Здебільшого, грибкові інфекції серйозно можуть загрожувати здоров'ю тих, хто має ослаблений імунітет. Наприклад, затяжний оніхомікоз (грибкове ураження стоп та нігтів) може призвести до загострення хронічних хвороб.
Лікар-дерматолог медичного центру «ОН Клінік Полтава» Катерина Манжула каже:
«Грибок — це не просто проблема, яка завдає певних незручностей. Це серйозне паразитарне зараження організму, здатне виступати як каталізатор всіх запальних процесів внутрішніх органів і систем. І насамперед грибок послаблює імунітет».
Кількість грибкових інфекцій з кожним роком зростає. Однією з причин того, що відбувається, вчені називають збільшення кількості ВІЛ-інфікованих осіб і тих, хто страждає на інші імунні захворювання.
Найбільш поширеними грибками-паразитами є гриби роду Cryticiccus neoformans, Сandida albicans, Mucoraceae sp. Вони здатні паразитувати на шкірі, волоссі, нігтях, а також вражати внутрішні органи та системи людини.
Як стверджують доктори медичних наук Львівського медичного університету, на кожні 10 клітин людського організму припадає вдвічі більше бактерій, грибів та вірусів різного походження. Поки людина здорова, включаючи повноцінне харчування, ризик зараження невисокий. За офіційними даними, 15-40% здорових людей є носіями грибкових інфекцій та можуть заразити інших. Як правило, улюбленим місцем дислокації грибків вважають слизові оболонки, шкірні покриви, нігті і навіть кров.
Додам: в організмі людини «живуть» як корисні, так і умовно-патогенні (здатні активізуватися тільки при настанні сприятливого середовища) та патогенні грибки. Якщо їх кількість у нормі (зберігається баланс) і ця норма перебуває на контролі у здорового організму, вони не здатні завдавати серйозної шкоди.
Грибки на шкірі та нігтях

Найлегше передаються грибки, що вражають шкірні покриви та нігтьові пластини. Серед найпоширеніших захворювань дерматологи відзначають мікози – група захворювань, що інфікують шкіру, волосся та нігті. Саме ці частини тіла щомиті тісно контактують з навколишнім середовищем, багатим на мікозні збудники (дерматофіти, трихофітони, дріжджові гриби роду Malassezia). Найчастіше люди стикаються з міжпальцевими мікозами, дерматомікозами волосся, стоп та шкіри через прямий контакт з інфікованими предметами (рушниками, постільною білизною, одягом), а також через тісний контакт із зараженими людьми чи тваринами.
До симптомів мікозу відносять почервоніння, лущення, свербіж у ділянці нігтя, шкірних складок на тілі, шкіри голови, стоп. При виявленні такої симптоматики одразу звертайтеся до дерматолога.
Уберегтися від грибка допоможе дотримання елементарних правил гігієни, використання своїх речей та приладдя у місцях громадського користування (бані, сауни, басейни). Якщо ви відвідуєте манікюрного майстра або перукаря, стежте за стерильністю його робочого місця та інструментів. При виявленні порушень, не погоджуйтесь на процедуру. Якщо член вашої сім'ї вже заражений, необхідно ретельно обробляти дезінфікуючими засобами місця спільного користування (ванна, туалет), прати постільну білизну та заражений одяг окремо від своїх речей.
Грибки у статевих органах
Поставте своє питання Дерматологу «ОН Клінік»
Грибки роду Candida у малій кількості присутні в жіночому та чоловічому організмі. У жінок і чоловіків вони можуть викликати кандидоз (молочницю): у слабкої статі уражається піхва, а у сильної – крайня плоть, головка статевого члена. Найчастіше Candida активізується на тлі ослабленого імунітету, внаслідок тривалого прийому антибіотиків, різкої зміни клімату, і на тлі порушень обміну речовин. Симптомами недуги виступає печіння та свербіж у ділянці статевих органів, біль під час сечовипускання, нехарактерні виділення.
Лікар-гінеколог медичного центру «ОН Клінік Харків» Алла Браславець зазначає:
«Часті стреси сильно знижують захисні функції організму, про що багато хто забуває. Якщо в такому організмі є грибкова інфекція, у тому числі із роду Candida, гриби без перешкод починають свою атаку».
Грибки у дітей

У дітей найчастіше грибки роду Candida вражають ротову порожнину та здатні викликати кандидоз або стоматит ротової порожнини (утворення білих виразок та нальоту на слизових). Грибкова інфекція може розвиватись навіть у новонароджених. Скажу, що причиною розвитку грибкової інфекції в цьому випадку може бути:
- неправильне годування;
- недостатня стерилізація сосок, прорізувачів для зубів чи дитячого посуду;
- сформована звичка малюка брати до рота всі предмети, які трапляються під руку.
У старших дітей молочниця найчастіше активізується на тлі зниженого імунітету і травмування ротової порожнини.
Лікар-педіатр дитячого відділення медичного центру «ОН Клінік Харків Палац Спорту» Тетяна Сирбу радить:
«Лікування грибкових інфекцій у дорослих та дітей засноване на використанні протигрибкових препаратів, загальнозміцнюючих процедур, спеціальної дієти (відмова від великої кількості вуглеводної їжі, дріжджових виробів, жирних та копчених страв) та дотримання правил гігієни. І, звичайно, схему лікування повинен підбирати лікар, виходячи з того, який грибок паразитує в організмі».
Грибок у внутрішніх органах
Шлунково-кишковий тракт та сечостатеві шляхи теж можуть постраждати від патогенного впливу грибка, частіше від роду Candida. Найчастіше кандидоз шлунково-кишкового тракту розвивається на тлі безконтрольного прийому антибіотиків, внаслідок серйозних порушень роботи імунної системи, і навіть через потрапляння всередину заражених продуктів (наприклад, через немиті овочі і фрукти). А ось кандидоз сечостатевих шляхів може з'явитися через цукровий діабет, перенесену операцію або наявність дренажу в сечових шляхах. Також причиною ураження сечостатевої системи грибкової інфекції є зниження імунітету.
А ще є дуже небезпечні грибки. Наприклад, грибок Blastomyces dermatitidis, може бути в повітрі і при попаданні в організм людини під час дихання здатний викликати бластомікоз. Це захворювання легень, яке може перетікати у гостру дихальну недостатність.
Не менш небезпечним вважається Sporothrix schenckii, який мешкає на чагарниках троянд, барбарису та інших садових культур. Грибок потрапляє всередину шкірних покривів людини через дрібні подряпини або порізи і викликає споротрихоз - рідкісну шкірну інфекцію, що найчастіше вражає область обличчя, рук і ніг.
Чи можна захиститись від грибів?
Звісно! Наш організм має власні мікроорганізми, які здатні підтримувати імунітет, але можуть бути знищені лікарськими препаратами. Найчастіше до цього призводить самолікування. Щоб не стати заручниками грибів, зміцнюйте імунітет, дотримуйтесь правил гігієни та своєчасно проходьте планові огляди у терапевтів, дерматологів, гінекологів та урологів. Якщо вже заражені, терміново починайте лікування.
Не дозволяйте корпорації Грибів стати володарями вашого організму!
У нашого блогу є власні канали в телеграмі та вайбері, в яких ми розповідаємо корисні та цікаві речі про здоров'я. Підписуйтесь, щоб зробити турботу про власне здоров'я та здоров'я сім'ї комфортною та легкою.
Дерматологія в ОН Клінік Полтава